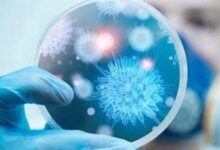

صحة
هل أدوية إنقاص الوزن تؤثر على البصر؟

وجدت دراستان أميركيتان ارتباطًا بين استخدام سيماغلوتايد أو تيرزيباتيد (Ozempic/Wegovy وMounjaro/Zepbound) وبين زيادة خطر اعتلال العصب البصري الإقفاري غير الشرياني (NAION) واضطرابات أخرى في العصب البصري لدى مصابي السكري من النوع الثاني—مع التأكيد أن الخطر المطلق منخفض. وفي حزيران 2025 خلصت وكالة الأدوية الأوروبية إلى أن NAION أثر جانبي “نادر جدًا” لدواء سيماغلوتايد (حتى 1 من كل 10 آلاف مستخدم). هذه بيانات رصدية لا تُثبت السببية، وبعض الأبحاث لم تجد زيادة معنوية؛ لذا تُوصى المراقبة البصرية، لا التوقف العشوائي عن الدواء.
تحليل سجلات طبية واسعة قارن مرضى سكري بادروا بسيماغلوتايد أو تيرزيباتيد مقابل أدوية أخرى؛ رُصدت زيادة في تشخيصات NAION واضطرابات العصب البصري، لكن الباحثين شددوا أن الخطر الإجمالي منخفض.
في السياق، دراسة وبائية أولى (2024) ربطت سيماغلوتايد بارتفاع خطر NAION نحو 4 مرات لدى مرضى السكري وحوالي 7–8 مرات لدى مستخدميه لإنقاص الوزن، تلتها دراسة أحدث أشارت إلى زيادة “طفيفة/متواضعة” وتحتاج لمزيد بحث.
وكالة الأدوية الأوروبية، أضافت NAION كأثر جانبي “نادر جدًا” لمنتجات سيماغلوتايد (Ozempic/Rybelsus/Wegovy)، ونصحت بإيقاف العلاج إذا تأكّد التشخيص.
مصدر الخبر
للمزيد Facebook